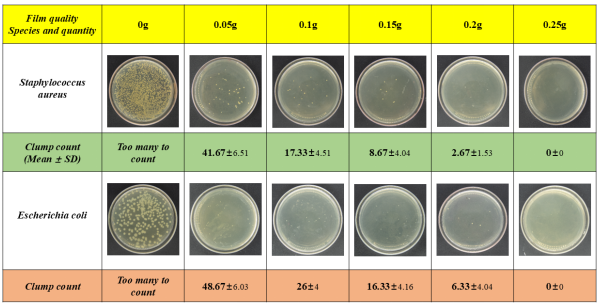
undefined undefined

(通讯员:游峰)塑料污染治理是当前全球面临的重大环境挑战之一。面对这一难题,我国已构建起全方位的政策支撑体系。工业和信息化部等七部门最新印发的《石化化工行业稳增长工作方案(2025-2026年)》明确提出,要支持高性能膜材料等领域的关键产品攻关,积极推动生物基材料在包装、纺织等场景的应用拓展。
近些年,郑华明教授课题组一直坚持“基础研究面向国际前沿,应用研究立足国家需求”的宗旨,通过生物技术、材料科学、环境工程、食品科学与分析化学等多个学科的深度交叉与融合,在生物降解材料和单一材质可循环利用方面取得了一系列的创新性成果。
系列研究成果介绍
成果一:发酵弱化BF/PBAT薄膜——利用黄粉虫实现塑料高效生物降解与土壤改良
PLA、PBAT、PBS、PHA等塑料凭借其可再生性和生物降解性,在市场端已经得到一定的推广应用。目前,国际上处理废旧可生物降解塑料一般通过堆肥降解的方式来完成。然而,堆肥降解仍存在一些局限性:为了优化降解效率,通常需要进行一系列复杂的预处理步骤,并且需要严格控制参与降解过程的微生物种类和数量及环境条件(包括温度、湿度、pH值和光照强度),否则降解效率大大降低;此外,堆肥降解需要建立专用的堆肥处理装置。

针对现有技术中存在的上述不足,提供一种发酵预处理辅助昆虫新陈代谢促进薄膜高效生物降解的方法,该方法能够加速PBAT(聚对苯二甲酸-己二酸丁二醇酯)塑料薄膜的降解,并且降解后的产物对自然环境不产生任何危害。

封面摘要

黄粉虫对不同处理方式薄膜的消耗量

黄粉虫代谢物在土壤掩埋过程中降解变化
在延长的幼虫期内,每100只黄粉虫对薄膜的消耗量接近300克,展现了巨大的生物处理潜力;经黄粉虫取食和肠道生物侵蚀后,PBAT组分的分子量降低了约10倍,实现了材料的大分子链断裂;黄粉虫吞食薄膜后的代谢产物被排入土壤,仅在4周内便促进了土壤的均质化,实现了“降解”与“改良”的双重目标。
本研究开创了利用环境中昆虫加速可降解塑料废弃物的新途径,是合成生物学、昆虫生态学与材料环境工程跨学科融合的典型范例。它为非粮生物质的高值化利用和有机废弃物(如秸秆)的协同处理提供了全新思路。
成果二:超声冷冻预处理竹纤维——打造长效抗菌且自降解的功能薄膜

超声冷冻预处理后竹纤维的比表面积达到20.37 m⟡/g,孔隙体积达0.1619 cm³/g,使其对肉桂精油的负载量提升至2.6%。调节竹纤维粉体表面特性,均匀分散与PBAT基体树脂中,通过熔融挤出,所得到薄膜不仅力学性能优异(拉伸强度31.003 MPa,伸长率376.599%),在接触与非接触两种模式下对金黄色葡萄球菌和大肠杆菌均表现出强大的抗菌活性。将其用于食品包装,展现出显著的保鲜效果,成功延长了食品保质期。同时,竹纤维的加入也加速了薄膜在土壤中的最终生物降解速度。

封面摘要

竹粉纤维素预处理前后微观形貌
BF/PBAT薄膜对大肠杆菌和金黄色葡萄球菌的抑制效果

不同保存方式下豆腐的腐败变化对比
本研究为生物降解材料在抗菌功能性方面提供了一种新的策略,实现了薄膜的自然降解与非接触式抗菌的统一。不仅响应了消费品“以竹代塑”的倡议,其长效抗菌特性对于保障食品安全也具有重要社会意义。
此外,该课题组在单一材质可循环利用方面,开发了一种聚烯烃高阻隔功能性薄膜,经历四次回收后,薄膜的纵向拉伸强度由29.66 MPa降至21.972 MPa,但仍保持良好的机械性能,证明了其回收可行性;研究同时发现,薄膜的阻隔性能在第二次回收后出现明显下降,这为后续材料改进指明了方向。与传统塑料相比,使用含有10%回收料的该单材质薄膜,每生产1.0吨产品可减少高达3692.25千克的二氧化碳排放。
未来,课题组将继续坚持跨学科联合研究的路径,密切关注并跟进国家相关部门在高性能膜材料、非粮生物基材料等领域的政策动向,致力于打通从基础研究到产业应用的“最后一公里”,期待与产业链上下游企业紧密合作,共同推动全球塑料污染的系统治理和循环经济体系的构建,从快速生物降解、功能化应用到物理回收减碳等方面提供多元化、多层级的解决方案。
全文链接:
https://doi.org/10.1016/j.cej.2025.169826
https://doi.org/10.1002/pc.70313
https://doi.org/10.3390/polym16152196
欢迎广大学子加入本课题组攻读硕士学位,课题组负责人郑华明教授邮箱:hmz_416@wit.edu.cn
审核:江学良
